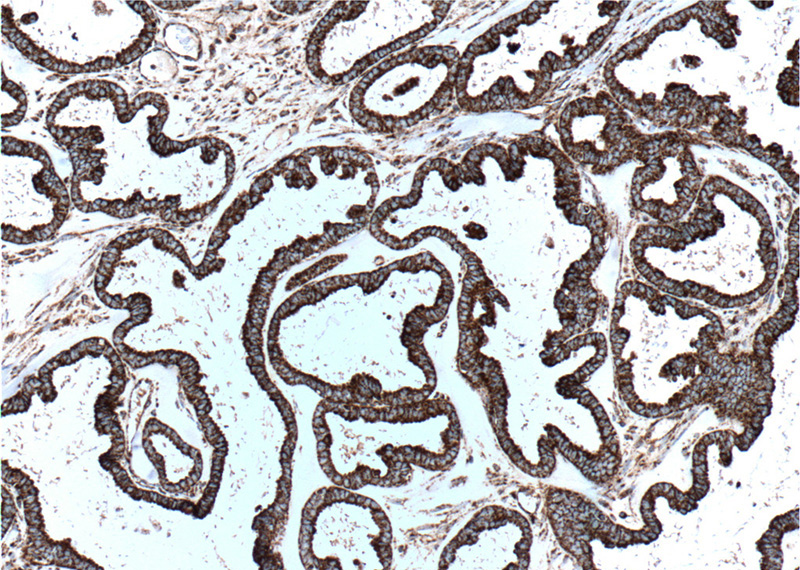
Immunohistochemistry of paraffin-embedded human ovary tumor tissue slide using Catalog No:107266(HSPD1 Antibody) at dilution of 1:500 (under 10x lens). heat mediated antigen retrieved with Tris-EDTA buffer(pH9).
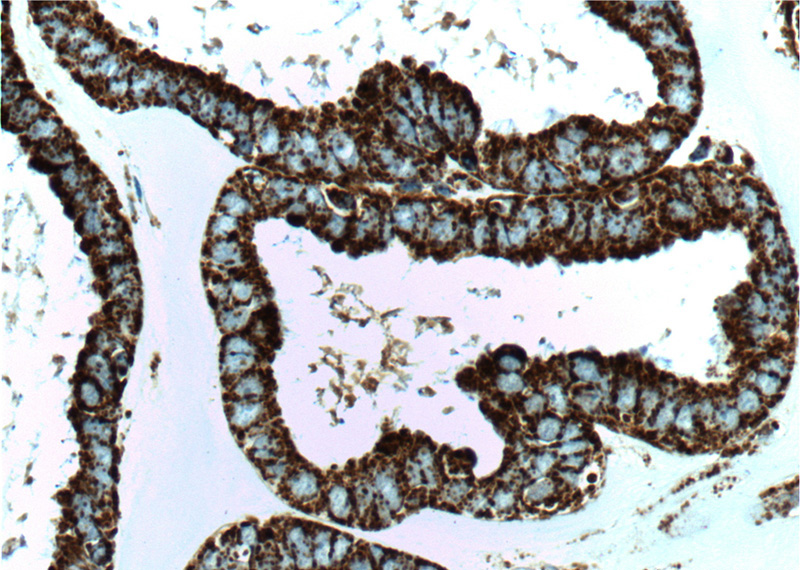
Immunohistochemistry of paraffin-embedded human ovary tumor tissue slide using Catalog No:107266(HSPD1 Antibody) at dilution of 1:500 (under 40x lens). heat mediated antigen retrieved with Tris-EDTA buffer(pH9).

-
Product Name
HSP60 antibody
- Documents
-
Description
HSP60 Mouse Monoclonal antibody. Positive WB detected in HeLa cells, HepG2 cells, MCF7 cells. Positive IP detected in mouse liver tissue. Positive FC detected in HeLa cells. Positive IF detected in Hela cells. Positive IHC detected in human ovary tumor tissue, human skin cancer tissue, human spleen tissue, human testis tissue, human tonsil tissue, human tonsillitis tissue. Observed molecular weight by Western-blot: 60 kDa
-
Tested applications
ELISA, IF, FC, IP, WB, IHC
-
Species reactivity
Human, Mouse, Rat; other species not tested.
-
Alternative names
Heat shOCk protein 60 antibody; HSP 60 antibody; HSP60 antibody; HSP65 antibody; HSPD1 antibody
-
Isotype
Mouse IgG1
-
Preparation
This antibody was obtained by immunization of HSP60 recombinant protein (Accession Number: NM_002156). Purification method: Protein A purified.
-
Clonality
Monoclonal
-
Formulation
PBS with 0.02% sodium azide and 50% glycerol pH 7.3.
-
Storage instructions
Store at -20℃. DO NOT ALIQUOT
-
Applications
Recommended Dilution:
WB: 1:1000-1:10000
IP: 1:1000-1:10000
IHC: 1:20-1:200
IF: 1:20-1:200
-
Validations

HeLa cells were subjected to SDS PAGE followed by western blot with Catalog No:107266(HSPD1 Antibody) at dilution of 1:4000

Immunofluorescent analysis of Hela cells, using HSPD1 antibody Catalog No: at 1:50 dilution and Rhodamine-labeled goat anti-mouse IgG (red). Blue pseudocolor = DAPI (fluorescent DNA dye).

IP Result of anti-HSPD1 (IP:Catalog No:107266, 5ug; Detection:Catalog No:107266 1:2000) with mouse liver tissue lysate 4000ug.
Immunohistochemistry of paraffin-embedded human ovary tumor tissue slide using Catalog No:107266(HSPD1 Antibody) at dilution of 1:500 (under 10x lens). heat mediated antigen retrieved with Tris-EDTA buffer(pH9).
Immunohistochemistry of paraffin-embedded human ovary tumor tissue slide using Catalog No:107266(HSPD1 Antibody) at dilution of 1:500 (under 40x lens). heat mediated antigen retrieved with Tris-EDTA buffer(pH9).

1X10^6 HeLa cells were stained with 0.2ug HSPD1 antibody (Catalog No:107266, red) and control antibody (blue). Fixed with 90% MeOH blocked with 3% BSA (30 min). Alexa Fluor 488-congugated AffiniPure Goat Anti-Mouse IgG(H+L) with dilution 1:1000.
-
Background
HSPD1, also known as HSP60, belongs to the chaperonin family and acts as a chaperone to enhance cell survival under physiological stresses. Hsp60 has been shown to be connected with many aspects of cell functions such as protein folding and assembling of polypeptide chains in mitochondria. Recently it has been reported that HSP60 is associated with apoptosis or inhibition of cancer cell growth. (21822415)
-
References
- Hu L, Su C, Song X. Tetrachlorobenzoquinone triggers the cleavage of Bid and promotes the cross-talk of extrinsic and intrinsic apoptotic signalings in pheochromocytoma (PC) 12 cells. Neurotoxicology. 49:149-57. 2015.
- Geng J, Sun X, Wang P. Kinases Mst1 and Mst2 positively regulate phagocytic induction of reactive oxygen species and bactericidal activity. Nature immunology. 16(11):1142-52. 2015.
Related Products / Services
Please note: All products are "FOR RESEARCH USE ONLY AND ARE NOT INTENDED FOR DIAGNOSTIC OR THERAPEUTIC USE"
